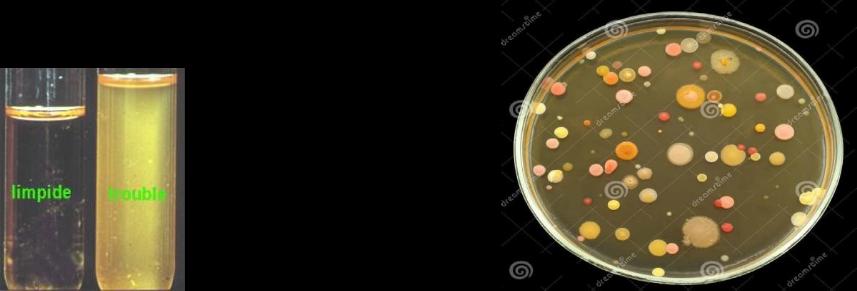
Colonies bactériennes

nutrition et croissance microbiologie
Advanced features available in the app
- Images
- Mathematical formulas
- Professional and academic diagrams in the app
Nutrition et croissance bactérienne en microbiologie
Cette fiche de révision couvre les bases essentielles de la nutrition bactérienne, les mécanismes de croissance, les milieux de culture, les facteurs influençant la croissance, les techniques de conservation microbiologique, les types respiratoires des bactéries et leur métabolisme énergétique. Elle s’adresse aux étudiants en microbiologie souhaitant comprendre les conditions nécessaires au développement bactérien et les méthodes utilisées pour leur étude et leur contrôle.
1. Nutrition bactérienne : besoins élémentaires
La croissance bactérienne dépend de la disponibilité de nutriments essentiels et de conditions physico-chimiques favorables. Ces éléments sont indispensables pour la synthèse des constituants cellulaires, le métabolisme et la reproduction.
1.1 L’eau : solvant vital
L’eau représente environ 70 % du poids d’une bactérie comme Escherichia coli. Elle est le milieu où se déroulent toutes les réactions métaboliques (cataboliques et anaboliques). La disponibilité de l’eau (activité de l’eau, [Formule]) est un paramètre clé influençant l’activité métabolique bactérienne.
1.2 Les éléments minéraux
Les bactéries ont besoin d’éléments minéraux en quantité suffisante, qui jouent un rôle structural (ex. : ions métalliques dans les enzymes) et fonctionnel (cofacteurs enzymatiques).
1.3 Sources de carbone
Le carbone est l’élément fondamental des molécules organiques (protéines, glucides, lipides). Les bactéries peuvent être classées selon leur source de carbone :
- Autotrophes : utilisent des composés inorganiques, notamment le dioxyde de carbone (CO[Formule]), qu’elles fixent et réduisent pour synthétiser leurs molécules organiques.
- Hétérotrophes : utilisent des composés organiques comme source de carbone.
1.4 Sources d’énergie
L’énergie nécessaire à la synthèse cellulaire provient de :
- La lumière : bactéries phototrophes.
- L’oxydation de composés organiques ou inorganiques : bactéries chimiotrophes.
1.5 Facteurs de croissance
Certains microorganismes ne peuvent pas synthétiser tous les composés organiques nécessaires et doivent les obtenir du milieu extérieur. Ces substances, appelées facteurs de croissance, comprennent :
- Acides aminés (synthèse protéique)
- Bases puriques et pyrimidiques (synthèse des acides nucléiques)
- Vitamines (coenzymes enzymatiques)
Selon leur besoin en facteurs de croissance, les bactéries sont :
- Prototrophes : ne nécessitent pas de facteurs de croissance (ex. : Escherichia coli).
- Auxotrophes : nécessitent un ou plusieurs facteurs (ex. : Neisseria gonorrhae, Légionella pneumophila pour la méthionine, Haemophilus influenzae pour deux facteurs).
| Classe du besoin | Nature du besoin | Type trophique |
|---|---|---|
| Source d'énergie | Lumière | PHOTOTROPHE |
| Oxydation de composés organiques ou inorganiques | CHIMIOTROPHE | |
| Source de carbone | Composé organique | HÉTÉROTROPHE |
| Composé inorganique ou minéral | AUTOTROPHE | |
| Facteurs de croissance | Non nécessaire | PROTOTROPHE |
| Nécessaire | AUXOTROPHE |
2. Croissance bactérienne : mécanismes et phases
La croissance bactérienne se traduit par une augmentation de la masse et du nombre de cellules, par reproduction asexuée appelée scissiparité.
2.1 La scissiparité : division cellulaire
La division bactérienne comprend deux étapes principales :
- Réplication du chromosome bactérien : semi-conservative, chaque brin d’ADN sert de matrice pour la synthèse d’un brin complémentaire. La réplication démarre à la fourche de réplication.

- Division ou scission : la cellule s’allonge, la paroi et la membrane se développent, puis un septum se forme, séparant les deux cellules filles génétiquement identiques.

Chaque cycle correspond à une génération, avec un temps de génération variable selon l’espèce.

2.2 Phases de croissance en milieu non renouvelé
En milieu fermé (non renouvelé), la croissance bactérienne suit un cycle en quatre phases :

- Phase de latence : adaptation au milieu, synthèse enzymatique, pas de multiplication.
- Phase exponentielle : multiplication rapide, taux de croissance maximal et constant.
- Phase stationnaire : équilibre entre bactéries nouvelles et mortes, masse stable.
- Phase de déclin : lyse et mort bactérienne dues à l’épuisement des nutriments et accumulation de déchets toxiques.
2.3 Paramètres de croissance
-
Temps de génération (G) : temps nécessaire pour doubler la population.
Exemples :- E. coli : 20 minutes
- Mycobacterium tuberculosis : 1000 minutes
-
Taux de croissance horaire ([Formule]) : nombre de divisions par heure.
Pour E. coli, [Formule].
Le nombre de bactéries après [Formule] heures est donné par :
[Formule mathématique]
Exemple : après 48 h, une bactérie E. coli donnera :
[Formule mathématique]
3. Milieux de culture : supports de croissance bactérienne
3.1 Définition et observation
Un milieu de culture est un mélange d’éléments nutritifs et de facteurs de croissance permettant la multiplication bactérienne.
- Sur milieu solide, la croissance forme des colonies visibles à l’œil nu, amas de bactéries issues d’une même cellule.
- Sur milieu liquide, la croissance provoque un trouble.
3.2 Types de milieux selon la consistance
- Milieu liquide : bouillons nutritifs en tubes, croissance en suspension.
- Milieu solide ou gélosé : bouillon additionné d’agar (polysaccharide extrait d’algues marines), permettant la formation de colonies sur boîte de Pétri.
3.3 Types de milieux selon l’utilisation
| Type de milieu | Description | Exemple |
|---|---|---|
| Milieux sélectifs | Inhibent la majorité des microorganismes, favorisent la croissance ciblée | Milieu CHAPMAN pour Staphylocoques |
| Milieux non sélectifs | Favorisent la croissance de nombreuses bactéries sans discrimination | Milieux d’identification, milieux de conservation |
-
Milieux enrichis : ajout de sang, extrait de levures pour bactéries exigeantes (facteurs de croissance).
-
Milieux d’identification : permettent la mise en évidence de caractères biochimiques.
-
Milieux de conservation : appauvris en nutriments, ralentissent la croissance bactérienne.
4. Facteurs physico-chimiques influençant la croissance bactérienne
4.1 Température optimale de croissance (TOC)
Chaque espèce possède une TOC spécifique :
- Psychrophiles : TOC < 20°C
- Psychrotrophes : 20–30°C (Listeria monocytogenes)
- Mésophiles : 20–40°C (E. coli, pathogènes humains à 37°C)
- Thermophiles : 50–60°C
Les températures extrêmes inhibent la croissance bactérienne.
4.2 pH optimal
- Acidophiles : pH < 7, ex. Lactobacillus
- Neutrophiles : pH = 7, ex. E. coli
- Basophiles (alcalophiles) : pH > 7, ex. Vibrio cholerae
La croissance est inhibée en milieu très acide, principe utilisé en conservation alimentaire (vinaigre).
4.3 Pression osmotique et activité de l’eau ([Formule])
- La paroi bactérienne protège contre les variations de pression osmotique.
- Certaines bactéries tolèrent des milieux salés (ex. Staphylococcus aureus dans milieu CHAPMAN à 7,5 % NaCl).
- L’activité de l’eau ([Formule]) varie de 0 à 1 : plus [Formule] est proche de 1, plus l’eau est disponible et la croissance rapide.
5. Techniques de conservation microbiologique
Ces méthodes visent à limiter ou empêcher la croissance bactérienne responsable de toxi-infections alimentaires.
5.1 Conservation par la chaleur
- Pasteurisation : destruction partielle des bactéries pathogènes.
- Stérilisation : destruction totale, mais certaines bactéries sporulées peuvent résister (Clostridium botulinum).
5.2 Conservation par le froid
- Réfrigération : ralentit la croissance.
- Congélation : cristallisation de l’eau réduit [Formule], inhibe la croissance mais ne tue pas les bactéries.
5.3 Conservation par déshydratation
La baisse de l’activité de l’eau est le facteur clé.
- Séchage : évaporation de l’eau.
- Fumage : déshydratation + action antimicrobienne.
- Lyophilisation : sublimation de l’eau à basse température.
5.4 Conservation par salage et sucrage
- Salage : abaisse [Formule] par le sel (fromages, charcuterie, poissons).
- Confisage : imprégnation en sucre (fruits confits, confiseries).
5.5 Conditionnement sous vide
Prive les bactéries d’oxygène, limitant la croissance des bactéries aérobies.
6. Types respiratoires des bactéries
La capacité à utiliser ou tolérer l’oxygène permet de classer les bactéries en quatre groupes :
| Type respiratoire | Description | Exemples |
|---|---|---|
| Aérobies strictes | Nécessitent l’oxygène | Neisseria |
| Aéro-anaérobies facultatives | Peuvent croître avec ou sans oxygène | Escherichia coli |
| Micro-aérophiles | Croissance optimale à faible concentration d’oxygène | Helicobacter pylori |
| Anaérobies strictes | Oxygène toxique, absence d’enzymes de détoxification | Clostridium |

7. Métabolisme bactérien : production d’énergie
Le métabolisme regroupe l’ensemble des réactions chimiques permettant la synthèse et le fonctionnement cellulaire. Le métabolisme énergétique repose sur des réactions d’oxydoréduction libérant de l’ATP.
7.1 Respiration bactérienne
- Respiration aérobie : accepteur final d’électrons est l’oxygène.
- Respiration anaérobie : accepteur final est un ion inorganique (ex. [Formule], [Formule]).
Ces réactions ont lieu au niveau de la membrane cytoplasmique via la chaîne respiratoire et le cycle de Krebs, avec un rendement énergétique élevé.
7.2 Fermentation : vie sans oxygène
La fermentation est une oxydation anaérobie où l’accepteur final est un composé organique sucré. Elle se déroule dans le cytoplasme et produit moins d’énergie.
Types de fermentation :
-
Fermentation alcoolique
Réalisée par des champignons comme Saccharomyces cerevisiae, transformant le glucose en éthanol et dioxyde de carbone, utilisée en brasserie et vinification.[Formule mathématique]
-
Fermentation lactique
Réalisée par des bactéries (streptocoques, lactobacilles), produisant de l’acide lactique à partir du lactose, acidifiant et coagulant la caséine (exemple : yaourts).[Formule mathématique]
8. Synthèse Mermaid : Types respiratoires et métabolisme énergétique
[Diagramme]
Conclusion : points clés à retenir
- La croissance bactérienne dépend de nutriments essentiels (eau, carbone, énergie, éléments minéraux, facteurs de croissance) et de conditions physico-chimiques optimales (température, pH, pression osmotique, activité de l’eau).
- La reproduction bactérienne s’effectue par scissiparité, avec un cycle de croissance en phases distinctes.
- Les milieux de culture sont adaptés selon la consistance et l’usage (sélectifs, non sélectifs, enrichis).
- La connaissance des types respiratoires et du métabolisme énergétique est cruciale pour comprendre la physiologie bactérienne et leur adaptation à l’environnement.
- Les techniques de conservation microbiologique exploitent la modification de l’activité de l’eau, la température, le pH et la disponibilité en oxygène pour contrôler la croissance bactérienne.
Cette synthèse offre une base solide pour comprendre la nutrition et la croissance bactérienne, essentielle en microbiologie fondamentale et appliquée.
